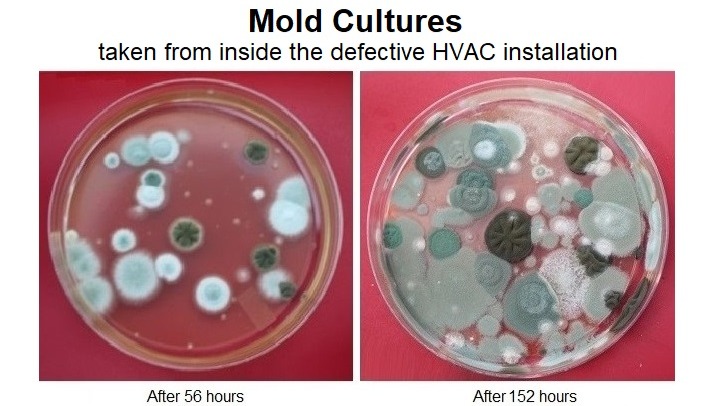

Scammed and Targeted for Exploitation by an NGO:
They've Nearly Killed Olivia, a Gem of Humanity.
Help Her Rebuild Her Life.
Help Her Shine.
Help Her Sing Again!
Dear Friends,
I'm reaching out to you on behalf of Olivia di Khetaa (keh-taw), a resilient woman whose life has been turned upside down by a devastating series of events. While Olivia has faced chemical intolerances (MCAS) which make travel by car a challenge for this otherwise strong, happy and fit woman, she has always managed to navigate life and bounce back with grace and determination. Unfortunately, a cruel twist of fate has left her in dire need of our support.
The above photos of Olivia illustrate how well she was just before the scam, even with her medical challenges.
Olivia is resourceful, creative, knowledgeable and musically talented, and has an impressive list of professional credentials and a vision for helping others in her community. Homebound with her medical challenges, she had been working tirelessly to establish a home-based business and a non-profit organization aimed at assisting others with special needs.
Those with special needs are modern day individuals “Canaries in the Coal Mine” who in response to ever increasing levels of pollution in our environment struggle far more than most of us, and serve all of us as an early warning system to the rest of us not so afflicted. In fact the University of Texas Health, San Antonio has determined that 1 in 5 people have Chemical Intolerance.
Olivia can be a leader and forerunner to find solutions and serve this underserved population. Please visit her website, Canary Refuge to learn more about this courageous woman and her mission: to help other “Human Canaries”. There, you can also hear this beautiful songbird singing with love, strength and courage!

Not long after the scam, she was forced to temporarily flee her home, but it was the scam which ruined her house, and exposes her to life threatening conditions. The scam contaminated her entire house and its contents with mold. She’s made progress cleaning it up, but still has no central air quality and climate control. Shown above is Olivia with oxygen mask and used trailer at the yard of a charitable host, far away from her home. Chemicals were applied near her house which off-gas non stop for months. Olivia is like that "canary in the coal mine." Because she could not breathe those gasses, she was forced to flee for her life.
That life threatening event has passed. Olivia has returned home, but still faces daunting threats and challenges left behind by the scammers, as you will see.
Firstly, your donation to this cause is a good investment: there will be a good return and the money will accomplish great things.
• Olivia is highly motivated. She wants to work and contribute to the greater good. Help her get back on her feet from this ordeal so she can realize her goal of helping others in her Human Canaries community.
• She is shining a light on the misuse of government grant funds. This has become a unavoidable service to the public she bears alone. Step by step she is winning! Her victory will put spotlight these scammers. Help put her over the finish line!
The Scam Against Olivia
In 2018 Olivia was prompted by her vision for Canary Refuge to embark on a plan to improve her home. It was then that she contracted with a large local charity/non-profit/NGO (non-government organization) to do just that. This organization advertised that it was able to perform a “HOME REHABILITATION” to repair, renew and bring her home up to building code standards, using federal housing grant funds. The NGO designed the scope of work and wrote the contract, then hired a separate contractor to oversee its field operations.
The purpose of the government funds to help Olivia improve her life is worthy of merit, but in this case, the NGO is corrupt. The joint operation between the non-profit and its field contractor resulted in the DE-HABILITATION of
• Olivia’s home,
• her health,
• her access to revenue producing career paths and business plans,
• and destruction of her financial plans.
Their joint operation loaded Olivia with
• debt,
• a property lien,
• the stress of a contaminated and non-functional heating and air conditioning (HVAC) system,
• and an ever increasing pile of legal expenses.
They used tax payer funded federal grant money to achieve all this.
In summary, they offered to help, but it was no accident that they instead financially exploited her, made her house uninhabitable, and now continue to abuse her and expose her to life threatening conditions.
They need to be made famous for what they did and for their refusal to remedy the destruction they caused.

(There are more photos below.)
A Fraudulent “HOME REHABILITATION”
They BOTCHED EVERYTHING.
Using government fund grant funds this NGO left some items in the contract unfinished, or in some cases not even started. Building code violations, breaches of contract, and substandard workmanship permeate every section of the contract work. They inspected and approved the activities of their field contractor. They authorized the full release of the federal grant funds they obtained to fraudulently pay themselves and their field contractor.
In particular, the contractor's faulty installation of a new HVAC (heating and cooling) system led to toxic mold contamination of Olivia’s entire home and its contents, including the spaces she was planning to use for self employment and her nonprofit organization. This has caused Olivia to have serious illness and allergic hypersensitivity. Still, she refuses to give up and knows she can inspire others with her recovery.
Check out these photos!
They illustrate only some of the damage and negligence.
• HVAC, heating and cooling system turned toxic
• Structural damage

• Electrical and plumbing hazards


• Faulty roof and gutter installation

• Extensive water damage


• Slippery, wobbly, uneven stairs up to deteriorating deck
and her home's front entrance

• Poor workmanship
They smeared paint onto the glass of this brand new front door they installed. At both the storm door and main door behind it, they hung them both crooked.

With these and other issues they abuse Olivia and have made her home not fully habitable. Without clean, quiet and comfortable climate control, Olivia was forced to relocate to a partially habitable cabin she planned to finish and use for her Canary Refuge. As a result constant exposure to mold, toxins and other allergens they left behind, her health has severely deteriorated, causing her to need hired help.
The Fight for Justice
After years of attempting to resolve these issues, Olivia had no choice but to file a lawsuit to hold the responsible parties accountable. The legal battle has drained her finances, adding to the burden of out-of-pocket medical expenses and costs involved in her efforts to mitigate the damages. Litigation has dragged on without resolution.
The NGO non-profit and its field contractor must be held accountable! Olivia should not have to live in fear of toxic exposures that are at times very serious. She cannot be forced to accept an inadequate lowball offer. She has to have the resources to take this case to court if necessary to get a fair and adequate settlement. She could lose “EVERYTHING” as this drags on. Due to mounting legal bills, she is not able to cover the cost of things she desperately needs to survive.
How You Can Help
Your generous financial support will help Olivia to:
• cover overwhelming legal expenses and the huge debt Olivia has accumulated as this has dragged on since autumn 2018; (The perpetrators of this rip-off need to be held accountable!)
• pay for out of pocket medical expenses; (which are also huge)
• secure a safe and habitable living environment;
• continue her work to establish a home-based business and non-profit organization;
• hire help.
Every donation, no matter the size, will make a significant impact on Olivia’s life. Together, we can help her regain stability, restore her health, and realize her dream of helping others in her community. Help her rebuild her life from this devastating ordeal.
Thank you for your compassion.
Thank you for your support.
DONATE!
Please hit that DONATE button.
SHARE!
Please hit that SHARE button too, and share this with your friends, family and communities.
Hear this beautiful songbird singing with love, strength and courage!

Organizer and beneficiary
Jack Stets
Organizer
Athens, OH
Oliva di Khetaa
Beneficiary

